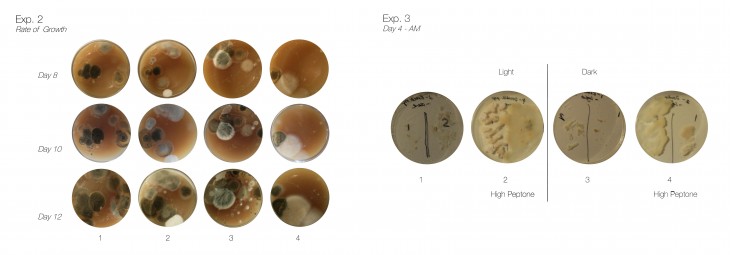

We imagine a city that is completely dark. In the periphery of the city, where there are fewer people on the streets the continuous illumination is not required. As people gravitate towards the urban center and populated areas, light is only generated where needed. Changing the energy module of the city, this urban illumination and energy production is closely tied to population density.
Introduction into Bioluminescent Bacteria
We believe that the future is moving towards a more advanced technological intelligence in which our devices and sustainable urban infrastructure will become more adapted to the human body of the user. No longer will there be static object and us, biology and technology are merging. From the beginning of human history, people have used technology to enhance the human experience and extend the abilities of our bodies. The overarching aim of technology is to improve human lives, in the past, in regards to nature and technology, humans have manipulated and ‘conquered’ their environment for their own benefit. Now our aim is to engage in a more symbiotic relationship with nature, by understanding the natural patterns and processes better.
Bacteria growth rate and experiment

Bacteria experiment
The whole existence of life on earth evolved from bacteria, and we house them by the trillions on or inside of our bodies. These bacterias are incredibly important to our survival and, often, they have the power to decide our fate. Their group-behavior suggest an intelligence far beyond what most of us can imagine and it is this intelligence we wanted to explore, learn from and develop a project based on our findings.

Bacteria setup and display
Wearable Living Light
We were fascinated by a specific type of marine bacteria known as Vibrio Fischeri that is housed in the light organ of the Hawaiian Bobtail Squid. The bacteria has a special quality of becoming bioluminescent, producing a light spectrum that falls within the range of 450-510 nm. However this glow is not the only interesting property of the bacteria, we are more concerned with the way the bacteria communicates in order to produce this light. When the cell density of the bacteria is low, it does not produce any light but by means of communication, known as quorum sensing, they are able to signal a single cell to sense the number of bacteria around and make a coordinated response to glow. All bacterias have a chemical language that they use to communicate with each other. They all have a species specific language that indicates who is in their colony and who is not.

Quorum sensing
Cellular Growth
Now designers and inventors alike are beginning to take a new approach on how to work with new technologies and materials. We are undergoing a paradigm shift, where we are engaging in a more collaborative and symbiotic relationship with biology and technology. We will need to incorporate living materials into our urban environment. It is no longer an ‘advanced’ architectural solution to only incorporate mechanical systems to control the climatic environment. As a response to this, we have designed a wearable substratum that houses the Vibrio Fischeri bacteria and re-introduces energy production into the public space. The bacteria is no longer luminescent in the squid but on our skin. Furthermore the light is activated by a person’s movement, thus the human body and the piece itself develop this symbiotic relationship.

Glassware design

Wearable substratum
Sharing Biolight
Bacterial communication is far more advanced than we can begin to understand and by studying this behaviour we achieved an insight into this communication of multicellularity and develop an analog model of communication in public space as a biomimetic inspiration of how people may interact in a city at night.
‘If the final frontier of design is to breathe life into the products and the buildings around us, to form a two-material ecology, then designers must unite these two worldviews. Here’s to a new age of design, a new age of creation, that takes us from a nature-inspired design to a design-inspired nature’. (Oxman, N. Design at the intersection of technology and biology.)

Proposed substratum that engages in a symbiotic relationship with the body and bacteria
Living Light – Bioluminescent Bacteria is a project of IaaC, Institute for Advanced Architecture of Catalonia developed at Master in Advanced Architecture in 2015 by:
Students: Thora H Arnardottir (Personal Website), Karthik Dhanabalan, Jessica Dias, Noor El-Gewely, Maryann Ewais, Ingried Ramirez.
Faculty: Claudia Pasquero (Introductory Studio Tutor), Carmelo Zappulla (Introductory Studio Tutor), Maria Kupstova (Introductory Studio Assistant).
